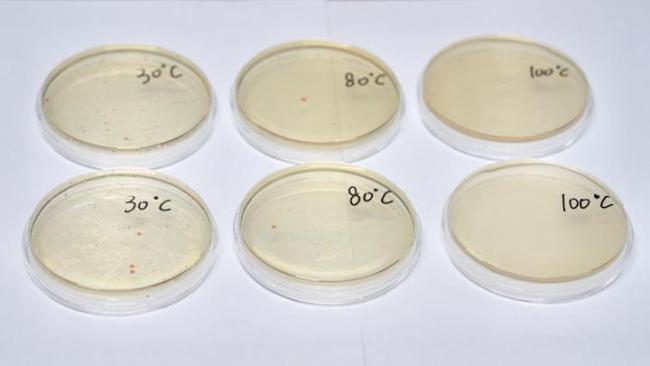
餐前烫碗是仪式感还是真管用 实验揭秘真相

去餐厅吃饭时,很多人习惯用热水烫碗筷。桐庐县检验检测中心为此做了一组实验,探究这种做法是否真的能有效杀菌。

研究人员准备了6只污染程度相同的碗,模拟日常的烫碗习惯,分别用30℃、80℃和100℃的水进行“快速烫”和“持续烫2分钟”处理。之后对碗中的菌落总数进行了检测,获得了6组实验样本。

结果显示,水温越高、烫洗时间越长,杀菌效果越好。使用100℃的热水烫2分钟的碗,细菌残留最少;而用30℃的水快速冲洗几乎没有任何杀菌效果,相当于没有烫洗一样,只能算是心理安慰。
实验证明,烫碗确实有一定作用,但要真正起到效果,水温和时间缺一不可。只有在高温和长时间烫洗的情况下,才能有效减少细菌。

在数字时代,朋友圈已演变为现代人的“数字门面”。社交平台调研数据显示,95后用户平均花费3.2小时制作跨年内容,有人甚至提前半个月开始筹备九宫格素材。这种“预制”行为体现了当代年轻人独特的社交密码
2025-12-31 09:39:33预制跨年腊月二十三,北京胡同里飘起糖瓜的甜香,灶王爷画像在火光中化为灰烬;同一时刻,湖南南县博物馆内,孩子踮脚拓印门神,老人手把手教包饺子
2026-02-10 21:11:19跟着年俗过大年